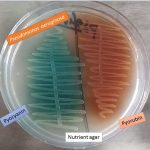
Pigment of Pseudomonas
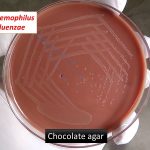
chocolate agar
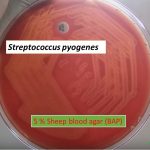
Blood agar

Collection Group: Clinical Bacteriology
Pseudomonas Pigment: Introduction, types and its details
Pigment production by Pseudomonas Pseudomonas aeruginosa produces a number of...
Pigment production by Pseudomonas Pseudomonas aeruginosa produces a number of...
Chocolate Agar: Introduction, Principle, Composition,Preparation, Colony Characteristics and Uses
Introduction of Chocolate agar Chocolate Agar (CHOC) is a non-selective, enriched...
Introduction of Chocolate agar Chocolate Agar (CHOC) is a non-selective, enriched...
Blood Agar: Introduction, Composition, Preparation, Principle and Interpretation, Uses , Types of Hemolysis and Keynotes
Introduction of Blood Agar Blood agar is an enriched medium...
Introduction of Blood Agar Blood agar is an enriched medium...
